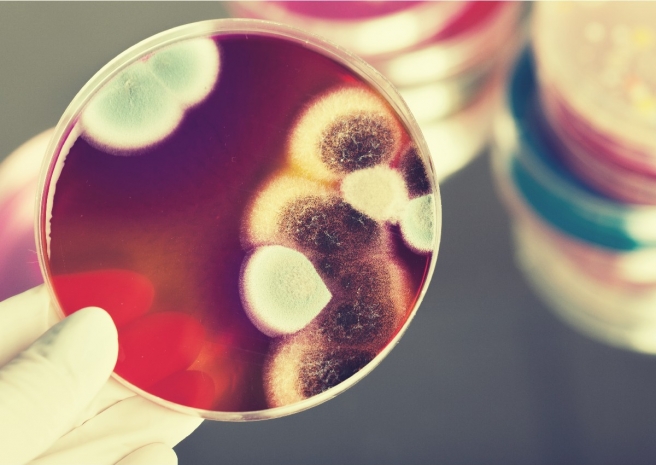
Об эпидемии «черной плесени» объявили в Индии

Добровольную стерилизацию предложили ввести в Индии
Для борьбы с перенаселением власти предложили добровольную стерилизацию.

422 статьи
Для борьбы с перенаселением власти предложили добровольную стерилизацию.

Лидером по числу заразившихся и скончавшихся от коронавируса остаются США.

Роботы занимаются дезинфекцией или осуществляют связь больных с врачами.

Ежегодно от ударов молний умирают около 2000 жителей Индии.

Лидером по числу заразившихся и скончавшихся остаются США.

Лидером по числу заразившихся и скончавшихся остаются США.

Лидером по числу заразившихся и скончавшихся остаются США.

Лидером по числу заразившихся и скончавшихся остаются США.

Индия остается на втором месте в мире по числу выявленных случаев заражения коронавирусом.

Лидером по числу заразившихся и скончавшихся остаются США.

Всего выявлено 20 случаев заражения новой мутацией в четырех районах штата.

Лидером по числу заразившихся и скончавшихся от коронавируса остаются США.

Лидером по числу заразившихся и скончавшихся от коронавируса остаются США.

Лидером по числу заразившихся и скончавшихся от коронавируса остаются США.

Лидерами по распространению и числу жертв коронавируса остаются США, Индия и Бразилия.

Власти индийских штатов Раджастан и Телангана объявили об эпидемии мукормикоза.
Число жертв с начала пандемии коронавируса достигло 3 413 801 человека.

Казахстан доставит в Индию медицинские маски, ИВЛ и СИЗ.

В число стран с более 10 миллионами случаев заражения COVID-19 входят США, Индия и Бразилия.

Лидером по числу заразившихся коронавирусом остаются Соединенные Штаты.
